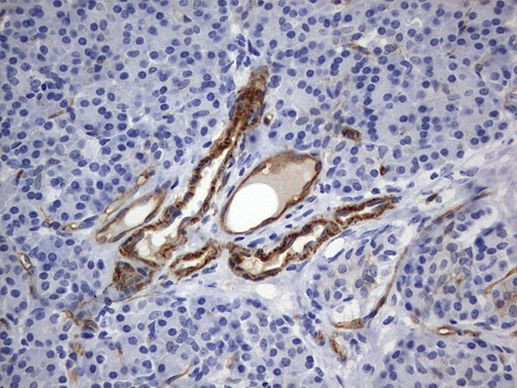
MCAM Antibody in Immunohistochemistry (Paraffin) (IHC (P))

Search
OriGene
MCAM Monoclonal Antibody (OTI2B2), TrueMAB™
{{$productOrderCtrl.translations['antibody.pdp.commerceCard.promotion.promotions']}}
{{$productOrderCtrl.translations['antibody.pdp.commerceCard.promotion.viewpromo']}}
{{$productOrderCtrl.translations['antibody.pdp.commerceCard.promotion.promocode']}}: {{promo.promoCode}} {{promo.promoTitle}} {{promo.promoDescription}}. {{$productOrderCtrl.translations['antibody.pdp.commerceCard.promotion.learnmore']}}
产品信息
TA803468
种属反应
宿主/亚型
分类
类型
克隆号
抗原
偶联物
形式
浓度
纯化类型
保存液
内含物
保存条件
运输条件
靶标信息
CD146, also known as MCAM (Melanoma Cell Adhesion Molecule), is an integral membrane glycoprotein belonging to the immunoglobulin superfamily. It is heavily glycosylated, with more than 50% of its mass derived from carbohydrates. CD146 is primarily expressed on endothelial cells at cell-cell junctions, playing a crucial role in cell adhesion and the cohesion of the endothelial monolayer in vascular tissue. In addition to endothelial cells, CD146 is expressed on bone marrow fibroblasts, mesenchymal stromal cells, endometrial stromal cells, and some tumors, particularly melanoma. It has also been observed on a subset of circulating T cells and activated lymphocytes, but not on circulating endothelial cells, as indicated by the absence of other endothelial markers such as CD31 and CD51/61. CD146 functions as a calcium-independent cell adhesion molecule and may also act as a signal transduction molecule. It is involved in the recruitment of Fyn kinase and the subsequent tyrosine phosphorylation of intracellular proteins, which are important for actin cytoskeleton assembly. This signaling role includes triggering tyrosine phosphorylation of FYN and PTK2 and causing a transient increase in intracellular calcium concentration. In the context of cancer, CD146 expression may facilitate the interaction of melanoma cells with the vascular system, enhancing hematogenous tumor spread. Additionally, CD146 could serve as an adhesion molecule active in neural crest cells during embryonic development, highlighting its diverse roles in both normal physiological processes and disease states.
仅用于科研。不用于诊断过程。未经明确授权不得转售。
篇参考文献 (0)
生物信息学
蛋白别名: CD146; Cell surface glycoprotein MUC18; Cell surface glycoprotein P1H12; Gicerin; melanoma adhesion molecule; Melanoma cell adhesion molecule; Melanoma-associated antigen A32; Melanoma-associated antigen MUC18; S-endo 1 endothelial-associated antigen
基因别名: CD146; MCAM; MUC18
UniProt ID: (Human) P43121
Entrez Gene ID: (Human) 4162